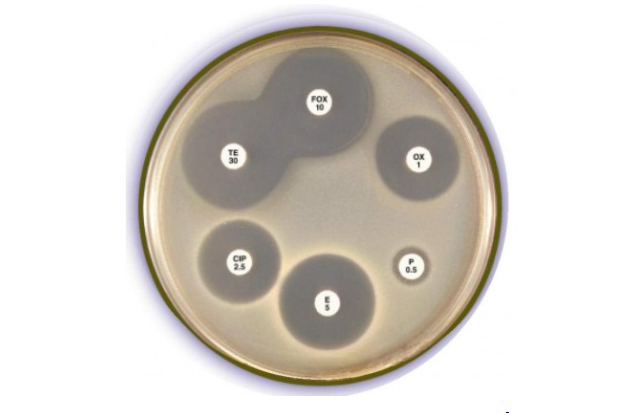
Xét nghiệm phân để làm gì?

Xét nghiệm phân để làm gì?


1. Xét nghiệm phân là gì? Khi nào cần xét nghiệm?
Xét nghiệm phân có vai trò quan trọng trong việc phát hiện sớm các bệnh về tiêu hóa. Xét nghiệm phân thường được dùng để xét nghiệm ở trẻ em. Với những trường hợp sau, bác sĩ sẽ yêu cầu xét nghiệm phân:
- Nhiễm trùng do những loại vi khuẩn, virus, hoặc các loại ký sinh trùng xâm nhập hệ tiêu hóa.
- Gặp phải một số rối loạn khi hấp thu đường, chất béo hoặc các chất dinh dưỡng khác.
- Nghi ngờ bị chảy máu bên trong đường tiêu hóa.
- Với trường hợp đặc biệt là khi tiêu chảy, thậm chí tình trạng này kéo dài hơn 2 ngày nhưng không có dấu hiệu giảm, đi ngoài nhiều lần và phân nhiều nước thì cần cho đi khám và xét nghiệm phân.
- Ở trẻ em phân bé có hiện tượng lẫn nhầy, có máu, mẹ sờ nắn bụng của trẻ khiến trẻ đau và kêu khóc. Trẻ nôn nhiều và rất khó để cho trẻ ăn uống.
- Nếu thấy trẻ có biểu hiện mất nhiều nước như mắt lõm, da nhăn và đi tiểu ít, khóc nhiều nhưng không có nước mắt thì mẹ nên cho trẻ đi khám càng sớm càng tốt.

2. Mục đích của xét nghiệm phân
Xét nghiệm phân được tiến hành nhằm:
- Giúp xác định các bệnh về đường tiêu hóa, gan mật, và tuyến tụy. Một số enzyme (như trypsin hoặc elastase) có thể được kiểm tra trong phân để giúp xác định chức năng tuyến tụy.
- Giúp tìm ra nguyên nhân của các triệu chứng ảnh hưởng trên đường tiêu, bao gồm: Tiêu chảy kéo dài, tiêu chảy ra máu, chướng bụng, buồn nôn, nôn, chán ăn, đầy hơi, đau bụng, chuột rút, và sốt.
- Phát hiện ung thư đại tràng bằng cách kiểm tra tìm máu lẫn trong phân.
- Phát hiện ký sinh trùng, chẳng hạn như giun kim hoặc Giardia.
- Giúp tìm ra những nguyên nhân gây ra nhiễm trùng, như do vi khuẩn, nấm, hoặc virus.
- Kiểm tra khả năng hấp thu các chất dinh dưỡng qua đường tiêu hóa.
Xét nghiệm phân cho trẻ sẽ giúp bác sĩ phát hiện những vấn đề sức khỏe của trẻ:
- Bằng cách soi phân, các bác sĩ sẽ tìm được nồng độ PH của phân, nấm, cellulose, cặn dư như tinh bột, tỷ lệ vi khuẩn đường ruột, có thể xét nghiệm ký sinh trùng với trường hợp cần thiết để tìm giun, sán,...
- Cấy phân với mục đích tìm vi khuẩn gây bệnh, có thể kết hợp làm kháng sinh đồ và xét nghiệm rotavirus,...
3. Quy trình xét nghiệm phân
Đối với trẻ lớn cần phải thu một mẫu phân để làm xét nghiệm. Có rất nhiều cách để lấy mẫu.
- Có thể đi tiêu vào một bọc nhựa bằng cách đặt bọc nhựa này trên bồn cầu và kẹp nó lại bằng nắp bồn cầu. Sau đó, lấy một mẫu phân bỏ vào trong một lọ đựng sạch.
- Bộ dụng cụ xét nghiệm có cung cấp giấy vệ sinh đặc biệt để giúp bạn thu thập mẫu. Sau khi thu thập mẫu phân, bạn cho mẫu phân vào trong lọ đựng sạch.
- Không để lẫn nước tiểu, nước, hoặc giấy vệ sinh trong mẫu phân.
Đối với trẻ em có mặc tã:
- Lót tã bằng bọc nhựa;
- Cố định bọc nhựa để tránh nước tiểu và phân bị trộn lẫn. Điều này sẽ giúp thu được mẫu phân tốt hơn.
4. Một số lưu ý trước khi tiến hành xét nghiệm phân
Một số lưu ý khi lấy phân tại nhà cho trẻ nhỏ:
- Đối với các mẫu phân mềm, nhão và có thêm màng nhầy hay máu thì không để chậm, nên xét nghiệm phân cho bé trong vòng 30 phút ngay sau khi mẹ lấy phân cho bé.
- Những trường hợp quá xa, cần phải bảo quản phân trong những dung dịch định hình. Chú ý không nên bảo quản trong nhiệt độ quá lạnh.
- Không lấy phân trong bỉm hoặc phân lẫn nước tiểu và nên cho bé đi vệ sinh vào bô sạch.

- Mẹ có thể dùng que lấy phân và cần đảm bảo là que sạch và đã được vô khuẩn. Trong quá trình lấy phân, nên lấy ở chỗ nghi ngờ nhất (nhầy nhớt, phân lỏng, có bọt, máu),... Mẹ nên lấy 10- 15g phân, sau đó cho vào lọ sạch và nhanh chóng đậy kín lại.
- Nếu cần tìm giun kim hoặc trứng giun thì có thể dùng tăm bông cho vào hậu môn của bé ngoáy và sau đó phết lên kính.
- Nếu cần tìm máu trong phân, mẹ không cho trẻ uống sắt, đồng thời kiêng thịt nạc khoảng 48 giờ trước khi lấy phân.
- Trong trường hợp cần cấy phân: Mẹ không nên dùng kháng sinh và các loại thuốc tiêu hóa ít nhất 2 tuần trước khi xét nghiệm và đồng thời phải vệ sinh hậu môn của bé trước và sử dụng dụng cụ vô khuẩn.
- Ở nhiệt độ lạnh, có thể bảo quản phân khoảng 4 đến 6 tiếng. Khi cán bộ đến lấy mẫu phân tại nhà, mẫu phân này tiếp tục được bảo quản và chuyển về khoa xét nghiệm.
Việc xét nghiệm phân khi trẻ nhỏ có các dấu hiệu bất thường về tiêu hóa là rất quan trọng. Cần bình tĩnh xử trí để đảm bảo cho con có một sức khỏe tốt nhất. Không nên lựa chọn những cơ sở kém chất lượng để xét nghiệm phân nhằm tránh rơi vào tình huống tiền mất, tật mang, rất nguy hại cho sức khỏe của trẻ nhỏ.

Ho rát họng có đờm là một vấn đề phổ biến có thể gặp ở bất kỳ ai. Nguyên nhân của tình trạng này có thể là viêm amidan, cảm cúm, viêm họng, thậm chí là ung thư vòm họng.
![[Góc giải đáp] Viêm Phế Quản Có Lây Không?](/uploads/suc-khoe/2023_12/viem-phe-quan-co-lay-khong.png&w=250&h=250&checkress=dccabc90558be2a987edc1d415786e89)
Viêm phế quản là một bệnh lý phổ biến trong xã hội ngày nay mà nhiều người có thể mắc phải. Tuy viêm phế quản không gây nguy hiểm đến tính mạng nhưng có thể ảnh hưởng đáng kể đến sức khỏe của người bệnh.

Ho, sốt đau họng là những triệu chứng thường gặp cùng lúc và có thể ảnh hưởng đến cuộc sống hàng ngày. Bài viết dưới đây sẽ làm rõ nguyên nhân, cách nhận biết và những phương pháp hiệu quả để giảm nhẹ và xua tan những triệu chứng này.

Là một phần quan trọng của hệ hô hấp, họng thường mắc phải nhiều bệnh lý khác nhau. Các bệnh về họng có thể đơn giản chỉ là viêm họng hoặc có thể nghiêm trọng hơn như viêm amidan, viêm thanh quản và thậm chí ung thư họng.

Thời điểm giao mùa, các trung tâm Y tế đang ghi nhận nhiều trường hợp bệnh nhi mắc viêm phổi do vi khuẩn Mycoplasma. Đây là một bệnh thường xuất hiện trong mùa giao mùa, đặc biệt làm lây lan nhanh chóng.

Ferritin là một loại protein dự trữ sắt và giải phóng sắt khi cơ thể cần. Ferritin tập trung chủ yếu trong các tế bào và chỉ có một lượng rất nhỏ lưu thông trong máu.

Xét nghiệm sắt huyết thanh giúp phát hiện nồng độ sắt trong máu thấp hoặc cao hơn bình thường.

Nếu bạn đang phải khổ sở vì những đêm trằn trọc mất ngủ thì việc ngủ được ngay chỉ sau vài phút nằm xuống giường quả là một niềm mơ ước. Tuy nhiên, thật sự có những cách giúp bạn có thể chìm vào giấc ngủ chỉ sau 120, 60 hoặc thậm chí là 10 giây.

Sắt là một khoáng chất cần thiết trong cơ thể con người. Sắt tham gia vào quá trình hình thành hồng cầu – các tế bào máu có nhiệm vụ vận chuyển oxy đi khắp cơ thể. Nồng độ sắt thấp hay thiếu sắt sẽ gây mệt mỏi và làm giảm khả năng chống lại nhiễm trùng của cơ thể. Nhưng điều gì sẽ xảy ra khi nồng độ sắt quá cao?














